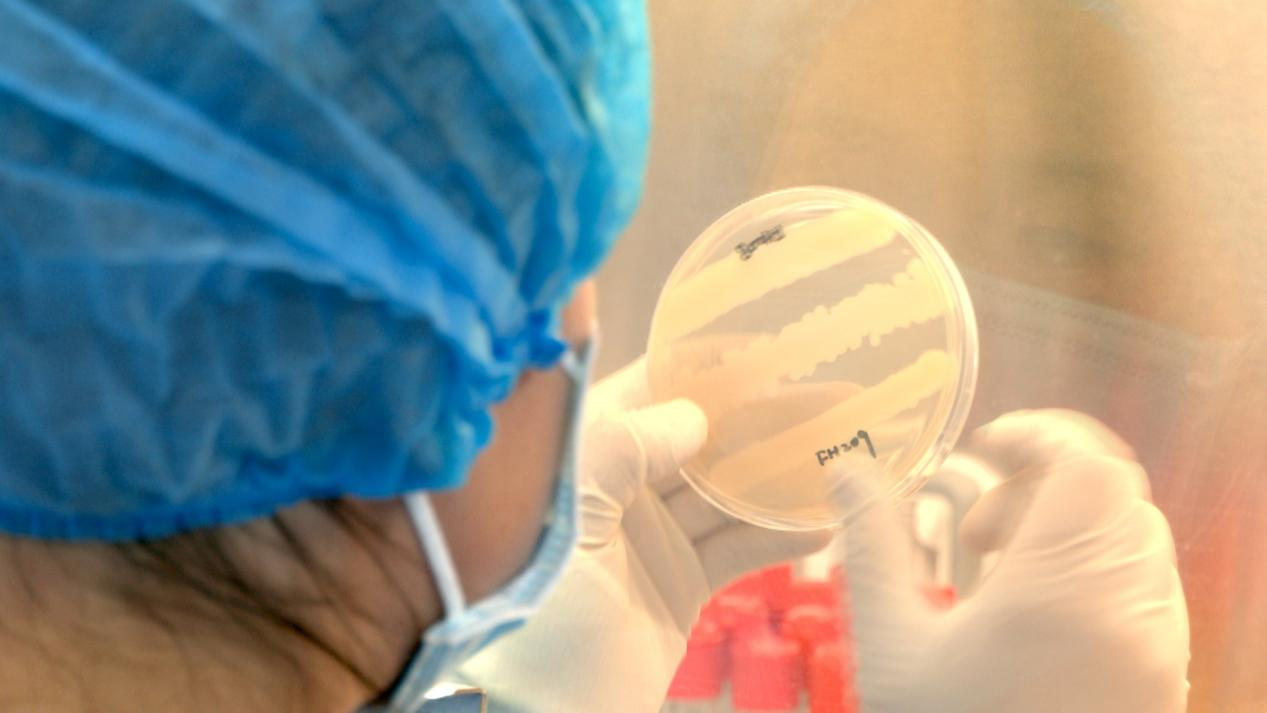

今年7月1日起正式施行的《贵州省科学技术进步条例》,针对科研人员反映强烈问题、立足贵州实际进行了全面“升级”,进一步巩固近年来贵州的科技体制改革成果。其中有哪些突破性条款?它们将如何更好地推动科技创新?我们去科研一线看看。
企业创新主体:有“干货”支持,“主角”地位更稳当!

这个界面是“39AI医生”上周刚更新的辅助功能,可以根据医生与患者问答实时录音整理,自动生成病历建议,省略了医生打字输入环节,进一步提高基层问诊效率。
“39AI医生”系统是贵阳朗玛信息技术股份有限公司自主研发、国内首个通过国家备案的医学大模型,目前已经在国内多家三甲医院接入使用,全面覆盖贵阳市186家基层医疗卫生机构。试点数据反馈,通过AI承担70%标准化工作,科室医患沟通时间平均延长12分钟。

企业总裁助理李笑凡表示,“39AI医生”已基本达到主任医师的专业水平。若要进一步提升,则需要更多罕见病和复杂疾病的医学数据进行训练。未来,数据采购将成为一项巨大的成本投入,相关费用是否能被纳入研发经费并享受优惠政策,此前一直存在争议。
对此,结合贵州大数据产业发展的实际需求,新修订的《条例》明确规定:企业采购数据用于研发的,其费用可视为研发投入费用,依照相关规定享受优惠政策。同时,《条例》进一步明确了企业在创新中的主体地位,提出了引导和支持企业与高等学校、科研院所联合开发技术及产品,共同组建创新平台等具体举措。

“我们明显感受到,今年接到了更多来自高校的合作邀请。”李笑凡表示,“目前我们正与贵州大学、贵州省人民医院携手共建先进医学成像与智能计算省级重点实验室。一旦取得成果,将显著弥补我们大模型在医学影像领域的不足,进一步接近世界前沿水平。”
对于企业创新主体而言,新《条例》提供了更大力度的扶持;而对于事业单位性质的科研机构来说,《条例》涵盖了多项从0到1的突破性举措,为成果转化有效“松绑”。

事业单位型科研机构:有政策“撑腰”,为科研“松绑”!
贵州医科大学是全省科技成果转化创新改革试点单位,近5年以知识产权作价入股进行转化项目4个,累计作价金额近7800万元,在此过程中试点探索的职务科技成果区别于有形国有资产、可以进行单独建账核算的管理制度,在《条例》中得到明确。
在此基础上,《条例》还提出,单位以职务科技成果作价投资入股企业的项目,鼓励做出贡献的科学技术人员、管理人员以跟投现金的方式持有股权。
贵州医科大学肿瘤免疫治疗技术工程研究中心团队负责人赵星这样描述其中的差异:过去,科技成果只能通过专利授权或转让给企业,这相当于将“孩子”交给别人,无法参与其成长。如今允许科研人员持股并参与企业运营,这一举措极大地消除研发人员对成果转化效果的担忧。

经过十余年的潜心研发,赵星团队在治疗肿瘤及自身免疫性疾病领域,成功研发出一种新型细胞药物——CAR-NK细胞。该药物的预期价格较市场上同类产品大幅降低,从每针约100万元降至10万元。目前,团队已将知识产权作价2000万元入股,并与投资人共同创立了贵州星博元生物医学科技有限公司,全力加速推动这一科研成果的落地应用。
赵星表示,预计今年年底将完成细胞制备生产车间的建设。目前,成熟的靶点仅有1到2个,为实现对更多疾病的治疗,仍需发掘更多靶点,因此研发工作正在持续推进,并需不断获得资金支持。
“科研人员持股的政策导向,包括开放现金跟投,企业可以与科研人员捆绑,形成一个利益共享、风险共担的共同体,投资人应该会更有信心,有望争取到更多市场支持。”赵星说。
据悉,本次《条例》修订尤为注重把贵州近年来先行先试、行之有效的典型经验上升为地方性法规,巩固全省科技体制改革试点成果。例如,《条例》从法律层面明确,鼓励科研机构科技人员流动到企业;科研机构与企业合作的横向科研项目经费可以提取和发放绩效奖励,单位制定的相关经费管理办法可以作为审计依据等,切实为科技人员“松绑”。
在贵州医科大学成果转化合作企业——贵州中森医药有限公司担任董事的技术经理人何明辉告诉记者,《条例》的出台为高校教师到企业兼职提供了法律依据,消除了以往参与企业经营时“多做多错”的担忧,使得他们更有信心放手去干,待项目落地并实现收益后,个人也能获得相应的经济回报。

《条例》还专门针对技术转移转化环节填补政策空白,首次明确要设置专业岗位,开展技术转移人才职称评定。
在贵州科学院,目前已经有54位技术经理人,但由于缺乏专业岗位设置,只能通过兼职承担成果转化工作。
“他们的工作业绩、职称通道怎么走?这些都是问题。”
科学院科研管理处副处长龙成昌认为,这次《条例》明确了技术转移转化人才人岗匹配,对于建立专业化的技术经理人队伍将会起到关键性作用,专业的人干专业的事,在金融、知识产权等方面为科研人员提供专业服务,更好助力科技成果转化。

贵州科学院具有自主知识产权的“贵科3D打印专用聚合物材料”
医疗机构:享受科研机构同等待遇 一起搞好科研任务!
《条例》特别提到,政府设立的医疗卫生机构开展科研,同样适用本条例规定,解决相关机构成果转化无章可循的问题。
贵州省疾病预防控制中心副主任李世军介绍,省疾控中心一直高度重视科研工作,内设传染病防治研究所、结核病防治研究所、慢性病防治研究所等机构,近3年来完成技术合同登记24个,其中19个项目已完成科技成果转化。
“像去年我们申报科研机构专项资金项目,由于我们不是按照科研机构来管理的,缺乏政策依据,最终没有获得资助。《条例》出台了以后就为我们课题申报、绩效分配等明确了方向。”李世军说。

目前,GG扑克 正在围绕《条例》建立政策落地兑现闭环服务长效机制,将相继完善细化落实措施,例如正在制定科研人员职务科技成果转化收益保障机制,着力解决容易产生争议的科技成果界定、科技成果定价、收益分配以及尽职免责认定问题,切实推动面向市场开展研发活动。